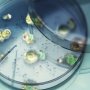

تجنب هذه الأخطاء الشائعة في علاج نزلات البرد

مع انخفاض درجات الحرارة وزيادة انتشار العدوى الفيروسية التنفسية الحادة، يلجأ الكثيرون إلى علاج أنفسهم بطرق غير صحيحة، مما قد يؤدي إلى تفاقم الحالة الصحية بدلاً من تحسنها. وفي هذا السياق، حذرت الدكتورة فريدة بيودين من أبرز الأخطاء الشائعة في التعامل مع التهابات الجهاز التنفسي الحادة:
استخدام المضادات الحيوية: يلجأ البعض إلى تناول المضادات الحيوية لعلاج العدوى الفيروسية، رغم أنها غير فعالة ضد الفيروسات. يمكن استخدامها فقط في حالة حدوث مضاعفات مثل التهاب الجيوب الأنفية أو التهاب الأذن الوسطى أو الالتهاب الرئوي. علاوة على ذلك، قد تؤثر هذه المضادات سلبًا على توازن البكتيريا النافعة في الأمعاء، مما يضعف جهاز المناعة.
خفض درجة الحرارة المنخفضة نسبيًا: ليس من الضروري خفض الحمى إذا لم تتجاوز 38.5-39 درجة مئوية في الأيام الثلاثة الأولى من المرض، حيث يساعد ارتفاع الحرارة في تعزيز استجابة الجسم المناعية. ومع ذلك، يجب مراعاة حالات كبار السن أو الأشخاص الذين لا يتحملون الحمى المرتفعة، وفي حال تجاوز الحرارة 39 درجة، يجب خفضها على الفور لتجنب المضاعفات مثل الجلطات الدموية أو فقدان الوعي أو مشكلات القلب والأوعية الدموية.
تناول أدوية مضادة للسعال دون داعٍ: استخدام أدوية تثبيط السعال قد يؤدي إلى تراكم البلغم في الجهاز التنفسي، مما يزيد من خطر التعرض لنوبات سعال حادة ومضاعفات أخرى.
إهمال الراحة في الفراش:بعض المرضى يستمرون في ممارسة أنشطتهم اليومية رغم الإصابة، مما يرهق الجسم ويضعف قدرته على مقاومة الفيروسات، ويزيد من خطر حدوث عدوى بكتيرية إضافية.
إغلاق النوافذ وتهوية الغرفة بشكل غير كافٍ: يعتقد البعض أن إبقاء النوافذ مغلقة أثناء المرض يساعد في التعافي، لكن العكس هو الصحيح. قلة التهوية تزيد من تركيز الفيروسات في الهواء داخل الغرفة، مما قد يطيل مدة المرض ويزيد من احتمالية حدوث مضاعفات.
الطريقة الصحيحة لعلاج التهابات الجهاز التنفسي الحادة
تشدد الدكتورة بيودين على ضرورة اتباع نهج صحي في التعامل مع نزلات البرد، وذلك من خلال:
الراحة التامة في الفراش.
اتباع نظام غذائي متوازن.
شرب كميات كافية من السوائل.
خفض درجة الحرارة فقط عند الضرورة.
غسل الأنف بمحلول ملحي لتخفيف الاحتقان.
استخدام القطرات المضيقة للأوعية الدموية لمدة لا تزيد عن 3 أيام في حالة احتقان الأنف الشديد.
الاعتماد على الأدوية المحللة والطاردة للبلغم عند السعال الرطب بدلاً من الأدوية المثبطة للسعال.
الالتزام بهذه الإرشادات يساعد في تسريع التعافي وتقليل خطر حدوث مضاعفات، مما يضمن استجابة أفضل للجسم في مواجهة الفيروسات.
للمزيد تابع خليجيون نيوز على: فيسبوك | إكس | يوتيوب | إنستغرام | تيك توك